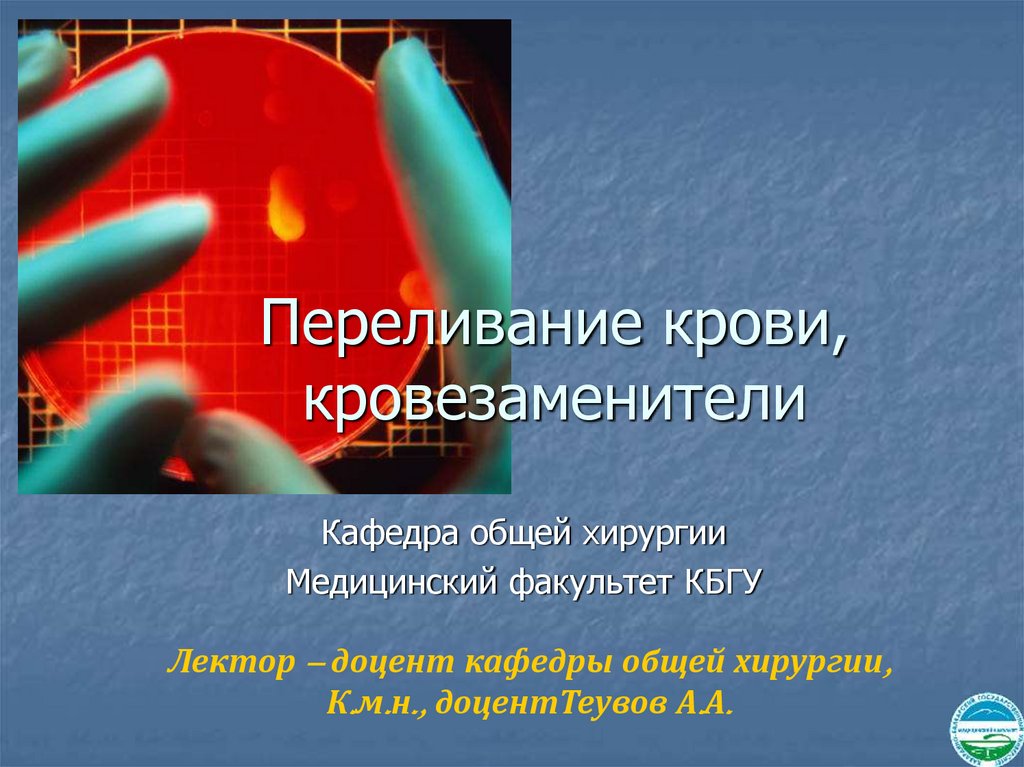

Similar presentations:
Переливание крови, кровезаменители
1. Переливание крови, кровезаменители
Кафедра общей хирургииМедицинский факультет КБГУ
Лектор – доцент кафедры общей хирургии,
К.м.н., доцентТеувов А.А.
2.
XI век – папа Иннокентий VIIIXVIII век – первое прямое переливание крови Ж. Дени
1847 г. – трактат А.М. Филомафитского «Трактат о
переливании крови как единственном средстве во
многих случаях спасти угасающую жизнь»
1901 г. – К. Ландштейнер открыл свойство агглютинации
(открытие 3-х групп)
1907 г. – Я.Янский повторил открытие (4-й группы)
1914 г. – Открытие А. Юстеном свойства цитрата натрия
1928 г. – В.Н. Шамов предложил переливание трупной
крови
1940 г. – К. Ландштейнер и А.С. Винер открыли Резус-фактор
3.
I – Эмпирический (вампирический)период до 1628 г.
II – Физиолгический период 1628 –
1901 гг.
III – Научный период 1901-1907 гг.
4. Трансфузиология (учение о переливании, смешении)
Раздел медицинской науки об управлениифункциями организма путем воздействия
на морфологический состав крови
переливанием компонентов крови,
кровезаменителей или
миелотрансплантацией (пересадка
костного мозга).
5. Группа крови-
Группа кровисочетание нормальных иммунологических игенетических признаков крови, наследственно
детерминированных, т.е. является
биологическим свойством каждого
индивидуума. Они передаются по наследству,
формируются на 3-4 месяце у плода, остаются
неизменными всю жизнь. Этих сочетаний
несколько млн. Группа крови определяется
перекрестным способом с помощью стандартных
эритроцитов, сывороток и цоликлонами.
6. РЕЗУЛЬТАТЫ определения группы исследуемой крови стандартными гемагтлютинирующими сыворотками
Группа исследуемойСодержание агглютининов в стандартных гемагглютинирующих сыворотках
крови
(IV) о
(I) α ,β.
(II) β
( III ) α
0 (I )
-
-
-
-
А ( II )
+
-
+
-
В (III)
+
+
-
-
АВ ( IV )
+
+
+
-
7.
РЕЗУЛЬТАТЫопределения группы исследуемой крови
стандартными эритроцитами
Группы исследуемой крови
Содержание в стандартных эритроцитах агглютиногенов
(I)0
(II ) А
(III) В
(IV) AB
0 (I) α ,β
-
+
+
+
А (II) β
-
-
+
+
В (III) α
-
+
-
+
АВ(IV) 0
-
-
-
-
8. РЕЗУЛЬТАТЫ определения группы исследуемой крови цоликлонами.
Группы исследуемой кровиЦоликлоны
Анти-А
Анти-В
Анти-АВ
0(I)
-
-
-
А (II)
+
-
+
В (III)
-
+
+
АВ (IV)
+
+
+
9. Причины ошибок при диагностике групповой принадлежности крови:
Низкое качество реагентов (срок годности, условияхранения, гниение и др.)
Технически ошибки (плохая освещенность,
температура окружающей среды,
расположение капелек, соотношение сывороток и
крови, несоблюдение времени (5 мин.),
недобавление физраствора и др.).
Особенности исследуемой крови (панагглютинация,
феномен Томсена).
10. Основные компоненты крови:
Эритроцитарная масса, ее получают путем осаждения форменныхэлементов крови путем центрифугирования или 24 часовым стоянием
флакона с кровью. Различают нативную эритромассу (срок хранения 21
день). Эритронаф (хранится до 35 дней), эритромасса, обедненная
лейкоцитами, тромбоцитами (ЭМОЛТ) - срок хранения 1 сутки. При
переливании эритромассы строго соблюдаются все правила.
Лейкоцитная масса - трансфузионная среда с высоким
содержанием лейкоцитов с примесью эритроцитов и тромбоцитов в
плазме. Хранится 1 сутки. Необходимо совпадение группы и резус
фактора. Биологическая проба обязательная.
Тромбоцитная масса - это плазма, обогащенная тромбоцитами,
готовят из свежей крови центрифугированием или путем
тромбоцитафереза. Срок хранения 1 сутки. Совпадение группы крови и
резус фактора обязательно. Биологическая проба не проводится.
Плазма. Бывает нативная (жидкая), плазма свежезамороженная (ПСЗ),
сухая, антигемофильная (АГП), антистафилококковая. Совпадение
группы крови и резус фактора и проведение биологической пробы
обязательны.
11. Абсолютные показания к гемотраснфузии:
Острая кровопотеря (более 15% ОЦК);- Травматический шок;
- Тяжелые операции с массивным
кровотечением;
- анемия
-
12. Относительные показания к гемотрансфузии:
ожоговая болезнь;сепсис;
хроническая анемия;
заболевания системы крови;
выраженная гнойная интоксикация.
13. Противопоказания к переливанию крови:
острая сердечно-легочная недостаточность(отек легких, острый инфаркт миокарда);
свежие тромбозы и эмболии;
тяжелые нарушения мозгового
кровообращения;
септический эндокардит, миокардиты,
пороки сердца;
острая печеночно-почечная
недостаточность.
14. ПРОБЫ НА СОВМЕСТИМОСТЬ ПЕРЕЛИВАЕМОЙ КРОВИ
Групповая совместимостьИндивидуальная совместимость
Резус- совместимость
Биологическая совместимость
15. МЕТОДЫ ПЕРЕЛИВАНИЯ КРОВИ
Прямое (непосредственное)переливание крови.
Непрямое (посредственное)
переливание крови.
Обратное переливание крови
(реинфузия и аутогемотрансфузия).
16. По путям введения методы гемотрансфузии делятся на:
1) внутривенный;2) внутриартериальный;
3) внутрикостный;
4) внутриаортальный.
17. К недостаткам непрямого метода переливания относятся:
a) потеря кровью некоторых целебныхсвойств в результате длительного
хранения;
b) удаление из крови отдельных ее
составных частей при
дефибринировании или катионной
обработке;
c) добавление к крови в известной
степени токсических веществ (цитрат
18. Классификация осложнений гемотрансфузии:
Осложнения механического характера:1.1. Острое расширение сердца.
1.2.Воздушная эмболия.
1.3. Эмболии и тромбозы.
2. Осложнения реактивного характера:
2.1 Постгемотрансфузионный шок при переливании
несовместимой крови.
2.2.Гемотрансфузионные реакции:
2.2.1.Пирогенные реакции.
2.2.2.Аллергические реакции.
2.2.3. Аналифактические реакции.
2.2.4.Цитратная и калиевая интоксикация.
2.2.5. Синдром массивных переливаний.
3. Передача инфекционных заболеваний: малярия, сифилис,
вирусный гепатит, СПИД.
1.
19. Переливание крови (гемотрансфузия)
Под ним подразумевается только переливание компонентов крови(эритроцитарная масса, тромобоцитарная масса и т.д.), т.к. переливание
цельной крови запрещено.
Методы переливания крови:
1. Прямое переливание крови с помощью специальных аппаратов
разрешается только с определения показаний к нему консилиумом
врачей в исключительных случаях.
2. Непрямое переливание - переливание предварительно
консервированной донорской крови.
2.1. Обратное переливание крови:
2.1.1. Реинфузия излившейся в закрытые полости крови пациента
2.1.2.Аутогемотрансфузия - обратное переливание
крови,
предварительно взятой у этого же
больного.
20. Аутогемотрансфузия
1. Отсутствиепостгемотрансфузионных
реакций
2. Экономический эффект
3. Стимулирующий эффект
21. Реинфузия
Показания:Острая анемия, угрожающая
жизни больного
Противопоказания:
Ранение полого органа.
Давность кровотечения свыше
12 часов
22. Алгоритм действия врача, переливающего кровь
1. Определить показания и противопоказания к переливанию крови.2. Собрать гемотрансфузионный и акушерский анамнез.
3. Определить групповую и Резус принадлежность реципиента.
4. Выбрать соответствующую донорскую кровь и определить ее годность к
переливанию.
5. Определить групповую принадлежность выбранной донорской крови,
независимо от данных этикетки флакона. Группа донорской крови и
реципиента должна совпадать.
6. Провести пробу на индивидуальную совместимость.
7. Провести пробу на Резус совместимость с 33% раствором полиглюкина.
8. Провести пробу на биологическую совместимость.
9. Перелить донорскую. Кровь (капельно!).
10. Оставить во флаконе 5-10 мл крови и сохранить флакон не менее 2-х
суток.
11. Произвести анализ мочи после переливания крови.
12. Произвести запись в историю болезни о результатах проведенных проб на
совместимость и переливания крови, № этикетки, дату заготовки,
фамилию донора.
13. Вести наблюдение за состоянием больного в течение 3 часов после
гемотрансфузии.
23. Кровезаменители
Это препараты, которые могутпри внутривенном введении их
в организм больного в
определенной форме заменить
лечебное действие донорской
крови.
24. Основные задачи кровезаменителей:
1. Заполнение сосудистого русла иподдержание на нормальном уровне ОЦК.
2.Освобождение организма от токсинов.
3. Обеспечение доставки питательных
белковых, жировых веществ, смеси
аминокислот всем органам и тканям
организма.
4.Устранение гипоксии (перфторан) и мн.др.
25.
КРОВЕЗАМЕНИТЕЛИА. Геммодинамические
— полиглюкин
— реополлиглюкин
— желатиноль
Б. Дезинтоксиционные
— гемодез
— поллиглюкин
— реоглюман
В. Регуляторы водно-солевого
состояния
— растворы NaCl
— Рингера - Локка
— лактосоль, дисоль, трисоль;
— маннитол
— сорбитол
Г. Для парентерального питания
Белкового
Жирового
1) полиамин
1) липофундин
2) альвезин
2) эмульсан
3) аминопептид
4) аминокровин
5) гидролизин
6) гидролизат козеина
Углеводного
1) р-р глюкозы
2) р-р декстрозы
Д. Переносчики кислорода
— растворы гемоглобина
— эмульсии фторуглеродов( перфторан)
Е. Комплексные кровезаменители
— на стадии разработки
26. Переливание крови (гемотрансфузия)
Под ним подразумевается только переливание компонентов крови(эритроцитарная масса, тромобоцитарная масса и т.д.), т.к.
переливание цельной крови запрещено.
Методы переливания крови:
1. Прямое переливание крови с помощью специальных аппаратов
разрешается только с определения показаний к нему консилиумом
врачей в исключительных случаях.
2. Непрямое переливание - переливание предварительно
консервированной донорской крови.
2.1. Обратное переливание крови:
2.1.1. Реинфузия излившейся в закрытые полости
крови пациента.
2.1.2.Аутогемотрансфузия - обратное переливание
крови, предварительно взятой у этого же
больного.
27. Компоненты и препараты крови
Показаний кпереливанию цельной
крови на сегодняшний
день не существует
В современной
трансфузиологии
утвердился принцип
компонентной
гемотерапии
28. Компоненты крови
Эритроцитная масса1.
Эритроцитарная масса (нативная)
2.
Эритроцитарная взвесь
3.
4.
Эритроцитарная масса, обедненная тромбоцитами и
лейкоцитами .
Размороженная и отмытая эритроцитарная масса
29. Компоненты крови
Лейкоцитарный концентратТромбоцитарный концентрат
30. Компоненты крови
Плазма кровиНативная плазма
Свежезамороженная
плазма
Лиофилизированная плазма
Плазма, бедная фактором
VIII
31. Препараты плазмы крови
Комплексные препараты1. Альбумин
2. Протеин
Корректоры свертывающей
системы
1. Криопреципитат
2. Протромбиновый комплекс
3. Фибриноген
4. Тромбин
32. Препараты плазмы крови
Препараты иммунологическогодействия
1. Гамма-глобулин для профилактики кори
2. Гамма-глобулин антистафилококковый
3. Антирезусный гамма-глобулин
4. Гамма-глобулин противогриппозный
5. Гамма-глобулин противостолбнячный.
33. Эритроцитарная масса
Достоинства:коррекция
анемических
состояний,
гипогмоглобинемии
коррекция
гематокрита
Недостатки:
тромбоэмболические
осложнения
возможная передача вирусов,
адсорбированных на мембранах
Er
возникновение
иммуносупрессивных состояний
развитие респираторного
дисстресс-синдрома
возможность НLA –
аллоиммунизации
развитие анафилактических
реакций
34. Тромбоцитарная масса
Достоинства:коррекция
тромбоцитопении
коррекция
тромбоцитопатии
Недостатки:
возможные
тромбоэмболические
осложнения
35. Свежезамороженная плазма
Достоинства:коррекция
гипопротеинемии
коррекция
коагулопатии
Недостатки:
не используется у
пациентов,
страдающих
непереносимостью
белков плазмы
необходимость
использования плазмы
совместимой по
системе АВО
недопустимо повторное
замораживание
36. Криопреципитат
Достоинства:коррекция
коагулопатий
применяется при
дефиците
фибриногена
Недостатки:
возможные
тромбоэмболические
осложнения
37. Схема инфузионно-трансфузионной терапии
Схема инфузионнотрансфузионной терапииСтепень
кровопотери
Объём
кровопотери
Препараты
I ст
<650 мл
ГЭК 650 мл
кристаллоиды 500 мл
II ст
650-1000 мл
ГЭК 650-1000 мл
кристаллоиды 1000 мл
38. Схема инфузионно-трансфузионной терапии
Схема инфузионнотрансфузионной терапииСтепень
кровопотери
Объём
кровопотери
Препараты
III ст
1000-2000 мл
гелофузин 800-1200 мл
кристаллоиды 1000-1500 мл
СЗП 250-500 мл
Эр.масса 250-500 мл
IV ст
>2000 мл
гелофузин 1200-1500 мл
кристаллоиды 1500-2000 мл
СЗП 500-1000 мл
Эр.масса 500-1500 мл

medicine
medicine








